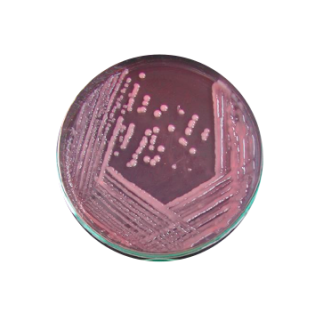
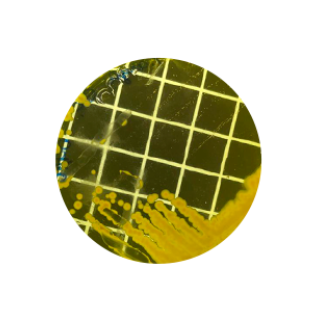
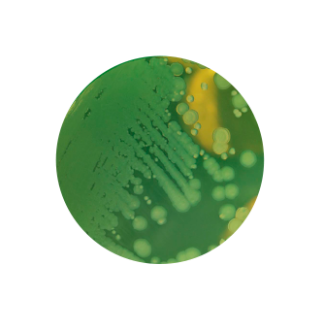
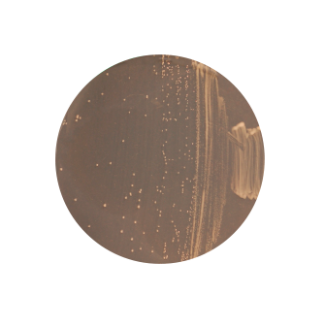
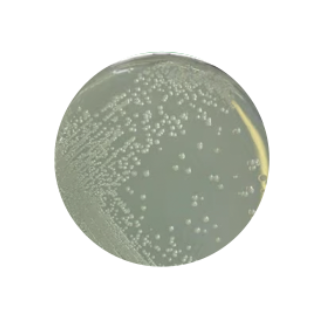
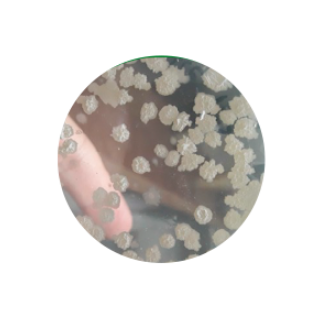

BLEND ZEA
Enraizamento, fixação associativa e sanidade
Azospirillum brasilense
Azospirillum brasilense
- Fixação associativa de N; fitormônios (auxinas).
- Tolerância a estresses; maior absorção de nutrientes.
Bacillus aryabhattai
Bacillus aryabhattai
- Reguladores de crescimento; melhor nutrição.
Pseudomonas spp.
Pseudomonas spp.
- Solubiliza P; sideróforos/antibióticos; ativa defesas.

Bradyrhizobium
Bradyrhizobium
Bacillus megaterium
Bacillus megaterium
Bacillus subtilis
Bacillus subtilis

 Bacillus amyloliquefaciens
Bacillus amyloliquefaciens